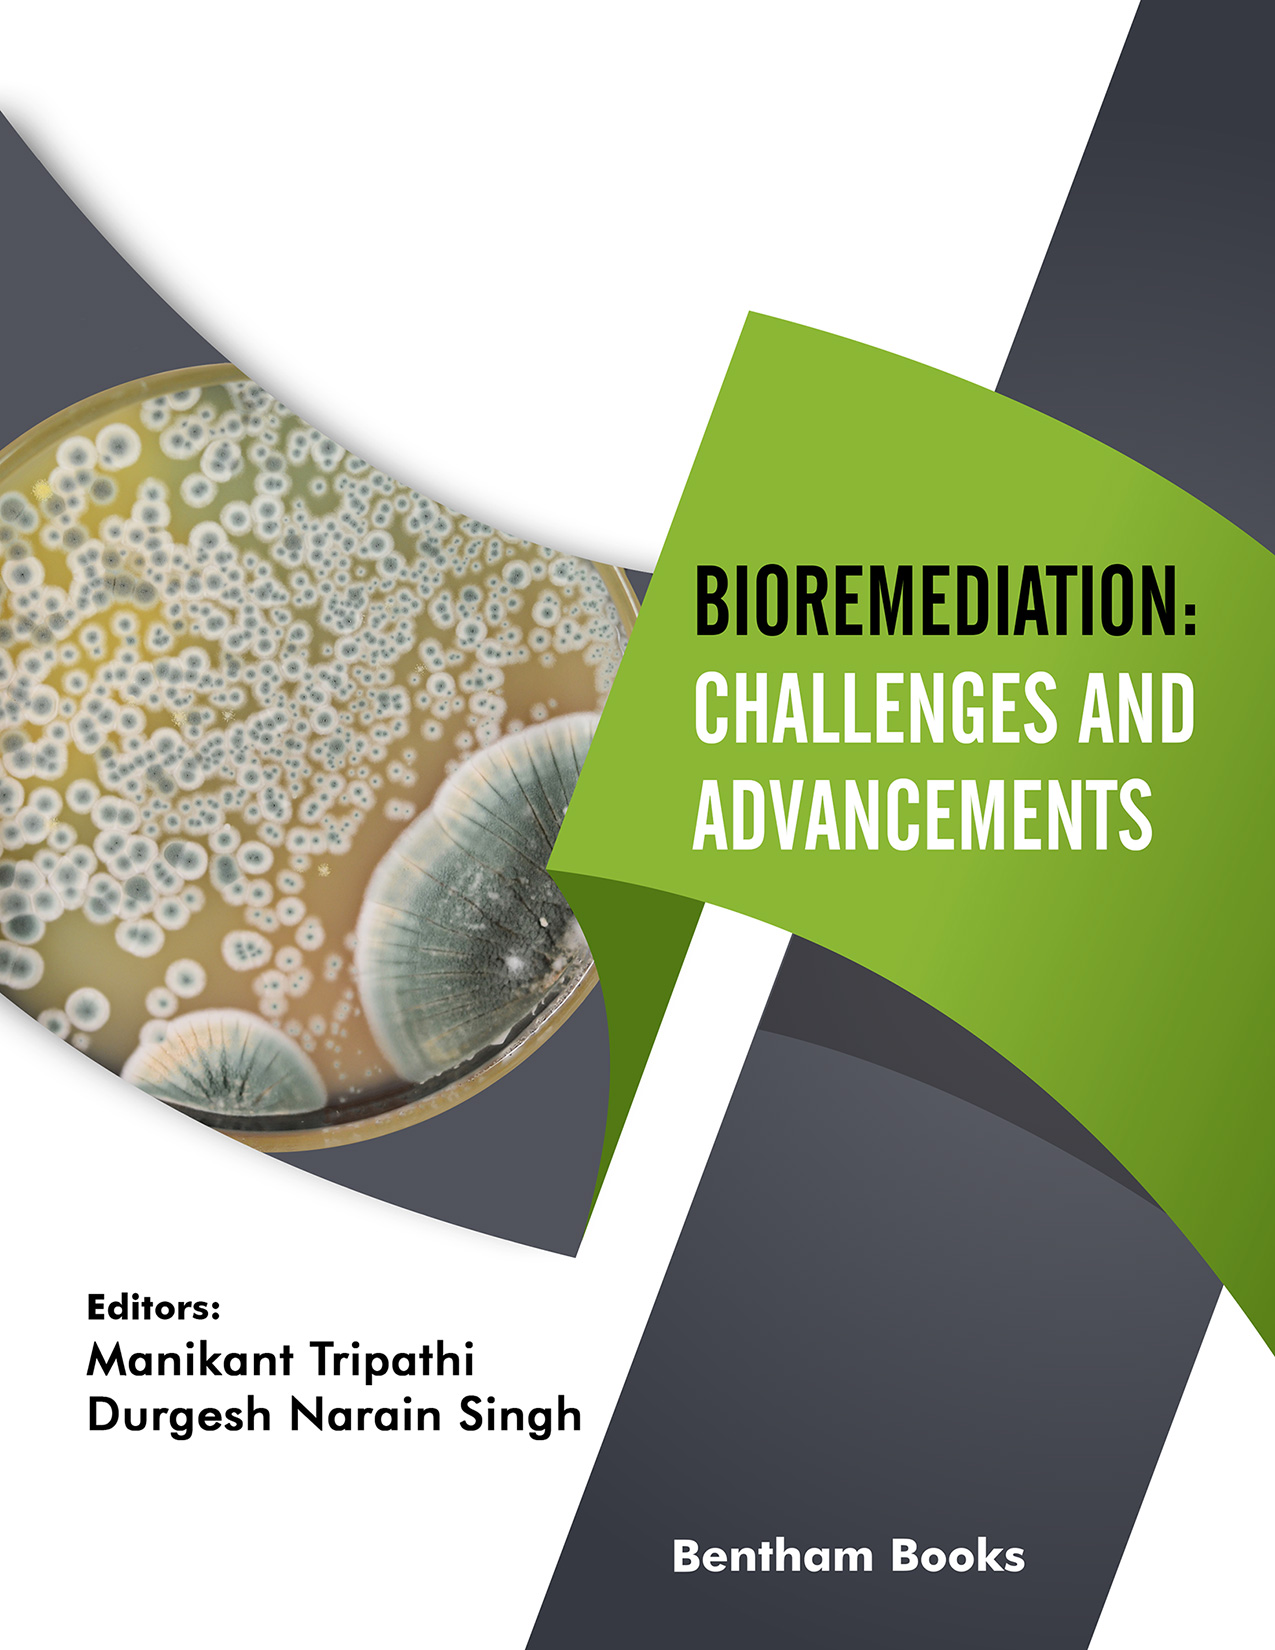

Bioremediation of Hydrocarbons and Xenobiotic Compound
- Authors: Suman Singh1, Sucheta Singh2, Ramesh Kumar Kushwaha3
-
View Affiliations Hide Affiliations1 Department of Botany, University of Lucknow 226007, India 2 Molecular Biology and Biotechnology Division, CSIR-National Botanical Research Institute,Lucknow-226001, India 3 Department of Biochemistry, REVA University, Bangalore-560064, India
- Source: Bioremediation: Challenges and Advancements , pp 1-48
- Publication Date: March 2022
- Language: English
In the last few decades, the increase in population, the industrial revolution, and modernization have produced numerous problems in the form of hazardous pollutants in the ecosystem rapidly. These hazardous pollutants such as polycyclic aromatic hydrocarbons (PAHs), heavy metals, manmade pesticides (xenobiotics), radioactive materials, toxic chemicals, and dyes created an imbalance in the ecosystem and increased risks to human, plants, and animal’s health. Furthermore, the use of chemical fertilisers, pesticides, and sewage releases toxicants into the soil and potable water, where they enter the food chain and endanger food security. Many strategies and practices have been used to prevent harmful effects of these pollutants up to a certain extent. Various physical and chemical methods have been implemented to remove these contaminants, but due to some limitations, it has not been applied successfully. Despite this, appropriate biological methods are currently applied to decrease pollutants’ concentrations from the soil, water, and the environment. The use of biological methods for bioremediation should be cost-effective, eco-friendly, and biodegradable, decreasing the danger to the ecosystem and living beings. Microbeassisted remediation technology has been developed to degrade xenobiotic compounds through various biosynthetic mechanisms. The objective of this chapter is to discuss different methods of bioremediation, their process, and mechanisms, employing potential plants and microbes in the remediation of pollutants from the environment. In addition, the present chapter highlighted the significance of recent biotechnological methods in improving the capability of microbial remediation methods. These methods successfully degrade pollutants, emphasizing current advances in microbe-assisted remediation along with phytoremediation as well as related challenges, future outlooks, and limitations.
-
From This Site
/content/books/9789815036039.chap1dcterms_subject,pub_keyword-contentType:Journal -contentType:Figure -contentType:Table -contentType:SupplementaryData105

